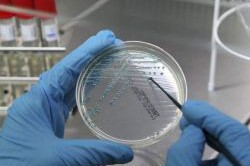
Взятие мазка Взятие мазка

Мазок из уретры берется у мужчин для проверки наличия микробов в мочеиспускательном канале и их количества. Результаты анализа на флору у мужчин позволяют определить, провоцируют ли имеющиеся микроорганизмы развитие инфекций и воспалений. Многих пациентов, которым никогда ранее не приходилось проходить данную процедуру, интересует, как берут мазок у мужчин, для чего берут материал на анализ, больно ли во время процедуры и о чем могут свидетельствовать результаты.
Какие болезни можно выявить с помощью мазка?
Мазок из уретры позволяет определить наличие воспаления, идентифицировать микроорганизмы, являющиеся возбудителем инфекций у мужчин, оценить состав микрофлоры. Таким образом, мазок из уретры прежде всего позволяет установить наличие таких воспалений и неспецифических заболеваний мужской мочеполовой системы, как:
- воспаление предстательной железы (простатит);
- воспаление мочевого пузыря (цистит);
- воспаление мочевыводящего канала (уретрит).
Специалист проводит взятие мазка, анализирует микрофлору и определяет, что именно стало причиной появления перечисленных заболеваний. Воспаление в простате, мочеиспускательном канале или пузыре может быть спровоцировано травматическими повреждениями и вредоносными микроорганизмами. В случае если заболевания вызваны травмами, это, как правило, определяется без специальных анализов, и забор мазка на флору у мужчин не проводится. Если же причиной инфекционно-воспалительного процесса в мужской мочеполовой системе стали микроорганизмы, то мазок из уретры сдают обязательно, т.к. с его помощью удается определить, какой именно микроорганизм является возбудителем, провести дополнительные исследования и назначить подходящее лечение.
Анализ мазок на флору позволяет определить и типы микроорганизмов, провоцирующих развитие основных инфекций мужских мочеполовых органов. В мазке у мужчин могут быть обнаружены такие инфекции, как:
- микоплазмоз;
- молочница (кандидоз);
- уреаплазмоз;
- мобилункусоз;
- хламидиоз;
- лептотриксоз;
- трихомониаз.
Помимо этого, в мазке у мужчин могут быть обнаружены бактерии, провоцирующие развитие неспецифического уретрита. Проверяется наличие золотистого стафилококка, сапрофитного стафилококка, кишечной палочки, эпидермального стафилококка и других микроорганизмов.
Мазок из уретры у мужчин является важной процедурой для диагностики различных инфекционных заболеваний, таких как гонорея, хламидиоз и другие половые инфекции. Врачи подчеркивают, что эта процедура позволяет получить точные данные о состоянии мочеполовой системы пациента. Мазок берется с помощью специального инструмента, который аккуратно вводится в уретру, что может вызвать кратковременный дискомфорт, но не является болезненным.
Специалисты отмечают, что ранняя диагностика инфекций позволяет избежать серьезных осложнений, таких как бесплодие или хронические воспалительные процессы. Кроме того, результаты анализа помогают врачам назначить правильное лечение и контролировать его эффективность. Важно, чтобы мужчины не стеснялись обращаться к врачу и проходили обследование, особенно если у них есть симптомы, такие как жжение или выделения. Регулярные проверки и своевременное лечение способствуют поддержанию здоровья и предотвращению распространения инфекций.

Как происходит взятие мазка?
Мазок берется достаточно просто и быстро. Прежде всего мужчине нужно тщательно вымыть область анального отверстия, промежность и пенис (в некоторых ситуациях ограничиваются лишь мытьем полового члена, это скажет специалист, который будет брать мазок). Кожа моется теплой водой с мылом, а затем тщательно прополаскивается чистой теплой водой и обсушивается стерильными марлевыми салфетками.
Осуществляется ввод инструмента в наружное отверстие в половом члене. Инструмент вводится в уретру на 2-4 см и 2-3 раза поворачивается вокруг своей оси. Затем он вынимается. Врач, при этом, совершает вращательные движения. После этого инструмент с взятым материалом помещается в стерильную пробирку либо же выполняется мазок на предметном стекле. Без учета гигиенических процедур взятие мазка занимает не более 1-1,5 минут.
Врач совершает вращательные движения инструментом для того, чтобы лучше собрать материал со стенок уретры.

Некоторым пациентам перед забором мазка из уретры проводится массаж мочеиспускательного канала или предстательной железы. Простата массируется через прямую кишку. Массаж мочеиспускательного канала выполняется с помощью плотного бужа. Врач вводит его в уретру на всю длину (порядка 10-11 см). Это позволяет увеличить чувствительность анализа и определить наличие заболеваний в давнишней, подострой, неявной или скрытой форме.
При заборе материала ощущаются дискомфортные, иногда немного болезненные, но терпимые ощущения.
В течение нескольких часов после сдачи анализа может ощущаться дискомфорт, зуд и умеренное жжение при мочеиспускании.
Как анализируется мазок?
Забранный материал наносится на специальное предметное стекло. В отдельных ситуациях, пока материал остается жидким, врач помещает его под объектив микроскопа. Как правило, это делается с целью обнаружения простейших микроорганизмов и движущихся частиц. В частности, подобный анализ является очень показательным для диагностики трихомониаза. Все структуры, содержащиеся в мазке из уретры, неподвижны, и лишь трихомонады могут самостоятельно совершать активные движения. Так что наличие движущихся микроорганизмов в анализируемом материале является патогномоничным для данной болезни.

Окрашивание мазка является основным этапом его анализа. Заметить какие-либо элементы в неокрашенном мазке очень сложно, т.к. в данном случае картина будет выглядеть как несколько прозрачных стекол, наложенных друг на друга.
Различить лейкоциты, бактерии и клетки можно только после окрашивания мазка при помощи специальных красителей. В зависимости от того, для каких целей сдается мазок, подбирается соответствующий краситель. К примеру, если мужчина сдает анализ на микрофлору, применяется краска по Граму, в случае же проведения цитологических исследований окраска проводится по методу Папаниколау. В основе методики лежит способность клеток по-разному реагировать на краситель. Под воздействием красителя невидимые элементы становятся заметными, и начинается изучение и дальнейшая расшифровка материала. В случае же если мужчина сдает мазок для выявления воспалительных заболеваний, материал анализируется под 900-кратным увеличением с использованием иммерсионного объектива микроскопа.
Мазок из уретры у мужчин — это медицинская процедура, которая может вызывать у пациентов различные эмоции и вопросы. Многие мужчины испытывают беспокойство и неловкость перед этой манипуляцией, так как она связана с интимной зоной. Однако важно понимать, что этот анализ необходим для диагностики инфекций, передающихся половым путем, и других заболеваний.
Пациенты часто отмечают, что процедура может быть немного неприятной, но она занимает всего несколько минут. Врачи объясняют, что мазок позволяет получить точные результаты и назначить правильное лечение. Некоторые мужчины, узнав о важности анализа, становятся более осведомленными о своем здоровье и начинают регулярно проходить обследования. В конечном итоге, понимание необходимости этой процедуры помогает преодолеть страх и стыд, делая шаг к более здоровой жизни.

Расшифровка и толкование результатов
В мазке из уретры у мужчин могут содержаться различные клетки и микроорганизмы. Важно знать, что должно присутствовать в материале, а что является сигналом об отклонении от нормы.
В мазке обнаруживаются лейкоциты. Они являются клетками иммунной системы и у здоровых мужчин присутствуют в мочеиспускательных каналах в небольших количествах. Нормой является содержание лейкоцитов в пределах 0-5 в поле зрения. Если количество лейкоцитов в мазке повышенное, то это, как правило, свидетельствует о наличии инфекции (простатита, уретрита).

Еще одним компонентом мазка является слизь. У здоровых мужчин она должна присутствовать в умеренных количествах. Избыток слизи свидетельствует о наличии инфекции.
Стрепто-, энтеро- и стафилококки являются условно патогенными микробами, т.е. они могут спровоцировать развитие заболевания лишь в определенных условиях. Они являются представителями нормальной микрофлоры человеческого организма и могут присутствовать в мазке в небольшом количестве. Повышенное содержание кокков, как правило, свидетельствует о наличии уретрита и иногда других заболеваний.
Гонококков в мазке здорового мужчины быть не должно. Их наличие свидетельствует о том, что мужчина болеет гонореей.
В мазке не должно быть и трихомонад. Простейшие трихомонады в анализируемом материале — это верный признак трихомониаза.
Что делать мужчинам с плохими анализами?
Если результат мазка из уретры оказался плохим, мужчине прежде всего нужно постараться подавить эмоциональную составляющую реакции и полностью сосредоточиться на дальнейших действиях. Слишком эмоциональное восприятие отрицательных результатов может спровоцировать множество других негативных последствий, наиболее распространенным из которых является желание убежать от проблемы, проигнорировав очередной поход к врачу, аргументируя это тем, что раз ничего не беспокоит, то на проблему можно не обращать внимание.

Одной из главных проблем воспалительных заболеваний мочеполовой системы является то, что незначительное время они протекают остро, с выраженными симптомами, однако довольно быстро хронизируются, приобретая вялотекущий характер. Клинические проявления, при этом, практически отсутствуют. В действительности же после острого периода патогенный микроорганизм поднимается из мочеиспускательного канала в простату и продолжает свою деятельность там. После ухода возбудителя из уретры исчезают выделения и болезненные ощущения, из-за чего многие мужчины ошибочно думают, что они выздоровели. А заболевание попросту ушло в простату и перешло в подострую форму, практически незаметную для больного.

Так что даже если у мужчины нет никаких выраженных симптомов, а результат мазка из уретры подтверждает наличие заболевания, это является свидетельством того, что в организме мужчины присутствует застарелый инфекционно-воспалительный процесс, на который он не обратил внимания в прошлом. Важно незамедлительно обратиться к врачу и пройти назначенный курс лечения. Будьте здоровы!
Вопрос-ответ
Что покажет мазок из уретры у мужчин?
Мазок из уретрального канала является скрининговым исследованием. С помощью этого теста можно быстро оценить состояние нижних отделов мочеполовой системы, выявить воспалительный процесс или инфекцию. Мужчинам желательно сдавать анализ ежегодно с профилактической целью.
Зачем мужчинам берут мазки из уретры?
Этот тест позволяет диагностировать инфекцию. Инфекции, выявляемые при исследовании мазка из уретры, часто передаются половым путём. К ним относятся хламидиоз, гонорея и герпес. Раннее выявление этих инфекций поможет избежать осложнений.
Как берут мазок у мужчин, больно или нет?
Многих мужчин перед сдачей анализа волнует вопрос, больно ли забирать мазок из уретры. Во время мазка, как говорят сами пациенты, ощущения не очень приятные, но терпимые. Во многом это зависит от квалификации врача, от используемых инструментов и от того, насколько сильное воспаление в уретре.
Что нельзя делать перед мазком из уретры у мужчин?
Правила подготовки к сдаче урогенитального мазка из уретры у мужчин: за 14 дней до исследования исключить прием антибактериальных препаратов. Перед сдачей анализа произвести тщательный туалет наружных половых органов. За 2 часа до исследования лучше воздержаться от мочеиспускания.
Советы
СОВЕТ №1
Перед процедурой мазка из уретры рекомендуется избегать мочеиспускания за 1-2 часа. Это поможет получить более точные результаты, так как в образце будет больше клеток и микроорганизмов.
СОВЕТ №2
Обязательно обсудите с врачом все принимаемые вами лекарства и возможные аллергии. Это поможет избежать нежелательных реакций и обеспечит более точную интерпретацию результатов анализа.
СОВЕТ №3
Не стесняйтесь задавать вопросы своему врачу о процессе взятия мазка и его значении. Понимание процедуры поможет вам чувствовать себя более комфортно и уверенно.
СОВЕТ №4
После процедуры следите за своим состоянием. Если вы заметили необычные симптомы, такие как боль или выделения, обязательно обратитесь к врачу для дальнейшего обследования.


